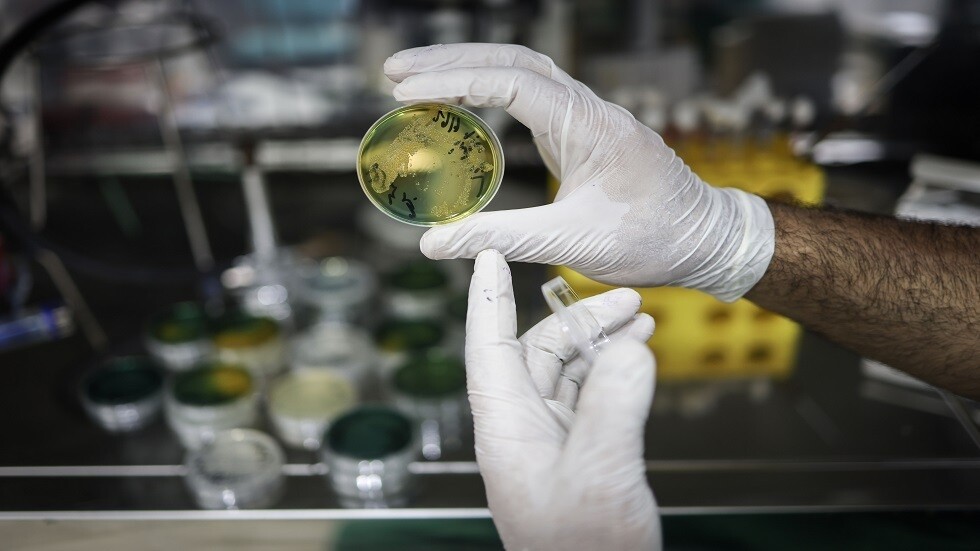
ارتفاع حالات الإصابة بالكوليرا حول العالم وسط نقص اللقاحات

Stories
-
نبض الملاعب
RT STORIES
الحكومة المكسيكية تعلن رسميا موقفها من استضافة إيران في مونديال 2026
#اسأل_أكثر #Question_MoreRT STORIES
حادثة سرقة تؤخر التحاق سعود عبد الحميد بمعسكر المنتخب السعودي
#اسأل_أكثر #Question_MoreRT STORIES
صلاح يختتم مسيرته مع ليفربول بتمريرة حاسمة ووداع مؤثر
#اسأل_أكثر #Question_MoreRT STORIES
من مصر 1934 إلى المغرب 2022.. رحلة العرب في كأس العالم بين الظهور المشرف ومقارعة الكبار
#اسأل_أكثر #Question_MoreRT STORIES
8 لاعبين من برشلونة وغياب تام لنجوم ريال مدريد.. دي لا فوينتي يعلن قائمة إسبانيا لكأس العالم 2026
#اسأل_أكثر #Question_MoreRT STORIES
بعد قيود قطر.. مونديال 2026 يغيّر قواعد المدرجات
#اسأل_أكثر #Question_MoreRT STORIES
سجدة شكر تتحول إلى جدل.. رومانو يخطئ في تفسير وداع صلاح
#اسأل_أكثر #Question_MoreRT STORIES
كرة تحتاج شحنا كهربائيا.. كرة "تريوندا" تدخل تاريخ كأس العالم
#اسأل_أكثر #Question_MoreRT STORIES
"الرقصة الأخيرة".. هل تحرم الإصابة ميسي من المونديال الأخير؟
#اسأل_أكثر #Question_MoreRT STORIES
بالفيديو.. حادثة غير متوقعة تفسد احتفالات سبارتاك بكأس روسيا
#اسأل_أكثر #Question_MoreRT STORIES
دجوكوفيتش يصنع التاريخ على عتبة الـ40.. رقم قياسي جديد في بطولات الغراند سلام
#اسأل_أكثر #Question_MoreRT STORIES
أمسية "فخر العرب" تشتعل في دبي
#اسأل_أكثر #Question_MoreRT STORIES
"أولمبياد المنشطات" ومليون دولار لتحطيم الأرقام.. بطولة جديدة تثير الصدمة (فيديو)
#اسأل_أكثر #Question_More
نبض الملاعب
-
العملية العسكرية الروسية في أوكرانيا
RT STORIES
الخارجية الروسية: سيتم ضرب مراكز القيادة وصنع القرار في كييف
#اسأل_أكثر #Question_MoreRT STORIES
مشاهد لمعارك تحرير القوات الروسية لبلدة دوبروباسوفو في مقاطعة دنيبروبيتروفسك
#اسأل_أكثر #Question_MoreRT STORIES
الدفاع الروسية تعلن تحرير بلدة جديدة شرق أوكرانيا
#اسأل_أكثر #Question_MoreRT STORIES
بيلاوسوف يتفقد قوات "الشرق" بمنطقة العملية العسكرية الروسية في أوكرانيا
#اسأل_أكثر #Question_MoreRT STORIES
إصابة مدني باعتداء أوكراني جنوب روسيا
#اسأل_أكثر #Question_MoreRT STORIES
"دوتكوم" يشن هجوما لاذعا على رئيسة المفوضية الأوروبية بعد الهجوم الإرهابي في لوغانسك
#اسأل_أكثر #Question_MoreRT STORIES
الدفاعات الجوية الروسية تدمر 33 طائرة مسيرة أوكرانية
#اسأل_أكثر #Question_MoreRT STORIES
خلاف بين قائد الجيش ووزير الدفاع الأوكراني حول توريد الأسلحة
#اسأل_أكثر #Question_MoreRT STORIES
قديروف ينشر مقطع فيديو يوثق عملية تصفية مسلحين أوكرانيين
#اسأل_أكثر #Question_MoreRT STORIES
القوات الروسية تحرر 3 بلدات جديدة في منطقة العملية العسكرية الخاصة خلال أسبوع
#اسأل_أكثر #Question_More
العملية العسكرية الروسية في أوكرانيا
-
فيديوهات
RT STORIES
إندونيسيا.. فيضانات تضرب منطقة باباكان مادانغ قرب جاكرتا
#اسأل_أكثر #Question_MoreRT STORIES
قطاع غزة.. حجم الدمار في حي "الشابورة" وسط مدينة رفح
#اسأل_أكثر #Question_MoreRT STORIES
مشاهد لناقلة الغاز "أركتيك ميتاغاز" التي هاجمتها المسيرات الأوكرانية في البحر الأبيض المتوسط
#اسأل_أكثر #Question_MoreRT STORIES
شاهد.. نجاة رياضية بعد اصطدام طائرة خفيفة بمظلتها الشراعية في الجو
#اسأل_أكثر #Question_MoreRT STORIES
جنازة جندي قتل بهجوم بطائرة مسيرة تابعة لحزب الله في شمال إسرائيل
#اسأل_أكثر #Question_MoreRT STORIES
قوات الأمن التركية تقتحم مقر حزب الشعب الجمهوري في أنقرة لطرد زعيمه بعد صدور حكم قضائي بعزله
#اسأل_أكثر #Question_MoreRT STORIES
سكان ستاروبيلسك يضعون الزهور على النصب التذكاري لضحايا هجوم المسيرات الأوكرانية على المدرسة المهنية
#اسأل_أكثر #Question_MoreRT STORIES
طائرات حربية أمريكية تحلق فوق كاراكاس في أول تدريبات منذ القبض على الرئيس نيكولاس مادورو
#اسأل_أكثر #Question_Moreفيديوهات
-
هدنة وحصار المضيق
RT STORIES
ترامب يطلب بصفة إلزامية من 8 دول عربية وإسلامية التوقيع الفوري على "اتفاقيات إبراهيم"
#اسأل_أكثر #Question_MoreRT STORIES
قائد الجيش الباكستاني يتوجه إلى الصين لبحث الوساطة بين واشنطن وطهران
#اسأل_أكثر #Question_MoreRT STORIES
"بلومبرغ": سفن الإمارات تلجأ إلى "العبور المظلم" لمضيق هرمز (فيديو)
#اسأل_أكثر #Question_MoreRT STORIES
البحرية البريطانية تستعد لتطهير مضيق هرمز من الألغام
#اسأل_أكثر #Question_MoreRT STORIES
الاتفاق بين واشنطن وطهران يدخل مرحلة الصياغة النهائية ويشترط تخلي إيران عن اليورانيوم المخصب
#اسأل_أكثر #Question_MoreRT STORIES
روبيو: إما نبرم صفقة جيدة مع إيران أو سنلجأ إلى البدائل
#اسأل_أكثر #Question_MoreRT STORIES
تقارير عن دخول مدمرات الليزر الأمريكية خط المواجهة لتعطيل "ترسانة إيران"
#اسأل_أكثر #Question_MoreRT STORIES
فوكس نيوز: واشنطن وطهران أنجزتا 95% من اتفاق إطاري محتمل
#اسأل_أكثر #Question_MoreRT STORIES
روبيو: ترامب لا يستبعد استئناف العمليات القتالية ضد إيران
#اسأل_أكثر #Question_MoreRT STORIES
كاتب إسرائيلي: الفشل الأمريكي في إيران يتحول إلى كارثة في إسرائيل التي تواجه أخطر وضع في تاريخها
#اسأل_أكثر #Question_MoreRT STORIES
الاتفاق بين إيران والولايات المتحدة بعيون إسرائيلية: التفاصيل وموقف تل أبيب.. من الخاسر ومن الرابح؟
#اسأل_أكثر #Question_More
هدنة وحصار المضيق
-
إسرائيل تواصل غاراتها على لبنان
RT STORIES
سموتريتش: اهدموا 10 مبان ببيروت مقابل كل مسيرة!.. وبن غفير: حان وقت الحرب المكثفة في لبنان!
#اسأل_أكثر #Question_MoreRT STORIES
جنوب لبنان.. حزب الله يستهدف صهريجا عسكريا إسرائيليا في مدينة بنت جبيل
#اسأل_أكثر #Question_MoreRT STORIES
رئيس الأركان الإسرائيلي يوجّه بضرب بيروت
#اسأل_أكثر #Question_MoreRT STORIES
نعيم قاسم: نزع سلاح المقاومة تجريد للبنان من مناعته الدفاعية وتمهيد للإبادة ولا نقبل به
#اسأل_أكثر #Question_MoreRT STORIES
معاريف: مسيرات "حزب الله" المفخخة تضع إسرائيل أمام تحد معقد.. الحلول قد لا تنفع
#اسأل_أكثر #Question_MoreRT STORIES
"حزب الله": استهدفنا قوة إسرائيلية متموضعة داخل غرفة في بلدة البياضة بمحلقة انقضاضية
#اسأل_أكثر #Question_MoreRT STORIES
17 قتيلا وأكثر من 30 جريحا في غارات إسرائيلية على جنوب لبنان والبقاع
#اسأل_أكثر #Question_MoreRT STORIES
"حدث كبير في الشمال ومقتل ضابط".."حزب الله" ينشر ملخص 28 عملية ضد إسرائيل في أقل من 24 ساعة
#اسأل_أكثر #Question_MoreRT STORIES
"يركض هربا من المسيّرة المفخخة".. مشاهد من استهداف "حزب الله" لجندي إسرائيلي (فيديو)
#اسأل_أكثر #Question_More
إسرائيل تواصل غاراتها على لبنان
"نُصحوا بعدم حضور جنازات المتوفين".. تفشي وباء الكوليرا بشكل مميت في بلد إفريقي
توفى مئات المواطنين وأصيب آلاف آخرون بعد تفشي وباء الكوليرا في زامبيا الواقعة في جنوب القارة الإفريقية.
وتجمع أقرباء المواطنين الذين يعالجون من المرض خارج ملعب بالعاصمة لوكاسا، في انتظار أي معلومات حول ما إذا كان أفراد عائلاتهم على قيد الحياة أم لا.
وقال نابل نيرونغا، لشبكة "سكاي" البريطانية، متحدثا عن جدته، "بالنسبة لنا، كنا ننتظر فقط خروجها من المستشفى. لكن للأسف، قيل لنا أنها توفت".
زارت وزيرة الصحة في البلاد، سيلفيا ماسيبو، المركز وعبرت عن تعاطفها مع المتضررين ونصحت بعدم حضور الأقرباء جنازات المتوفين بسبب المرض.
وفي وقت سابق، حث الرئيس الزامبي هاكايندي هيشيليما، الناس على الخروج من المدن والعودة إلى المناطق الريفية، حيث لا تزال المدارس مغلقة لمنع المزيد من الانتشار.
President of Zambia @HHichilema was caught off guard as he is failing to contain cholera. His health system has been exposed. They are making wooden makeshift wooden beds to admit the patients. pic.twitter.com/FP6gBZzdlF
— Dee Maphosa (@deemposa) January 13, 2024
ارتفاع حالات الإصابة بالكوليرا حول العالم وسط نقص اللقاحات
وأبلغت "سكاي" عن 351 حالة وفاة وما يقرب من 9 آلاف حالة عدوى. وجسلت حالات من الإصابة بالكوليررا في زمبابويه وموزامبيق المجاورتين أيضا.
وينتقل المرض عن طريق تناول الطعام أو الماء الملوث.
ويعتقد أن تغير المناخ كان سببا في هطول الأمطار الغزيرة التي لوثت مياه الشرب لأولئك الذين يعيشون في المناطق المزدحمة والأكثر فقرا.
وارتفعت حالات الإصابة بالكوليرا العام الماضي، وفقا للبيانات الأولية الصادرة عن منظمة الصحة العالمية، التي سجلت 4000 حالة وفاة بالكوليرا و667 ألف حالة إصابة على مستوى العالم.
المصدر: "أسوشيتد برس"
التعليقات